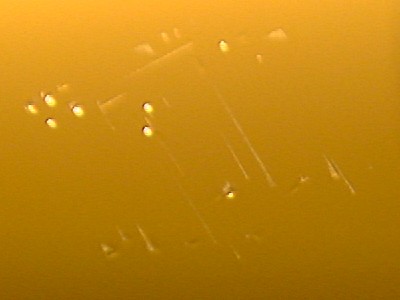

Feltehetően esés utáni nyom látható a képen.

Szintén esés miatt a felületen "ugrált" a fej.

A
lemez külső felén megtapadt fej indulásakor
sértette meg a
felületet.

Parkoló
pályán minden leálláskor megtapadó fej
az induláskor spirálisan
felsértette a felületet.

Feltehetően
megrázhatták a merevlemezt. Így a felületen
megtapadt fej közel
egymáshoz több helyen is letapadt.

A felső képeken szintén esés nyomai láthatóak.

Parkoló
pályán letapadt fej deformálódott karral
okozta a fent látható
sérüléseket.

Parkoló
pályán letapadt fej a kar deformációja nélkül
képes ilyen
látványos "sorminta" készítésére.